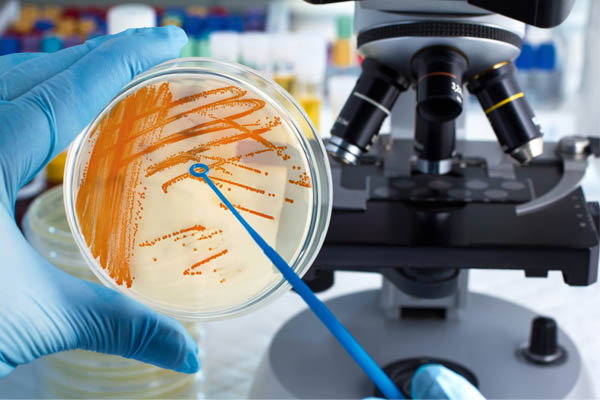
img

Professional Excellence
Xcellogen Biotech India Pvt Ltd is one of a leading biotech company in south India.

Where Science and Technology Meets
Our goal is to exceed customer needs and in-hand lab training to students as well as for Researchers from Bioscience Field.
Professional Editing
We are maintaining a group of scientists and writers from each and every field of Science and Technology to assure the quality of services
Better Platform
Xcellogen Biotech India provides better environment for doing your work whether its Wet lab or Dry Lab everything under one roof.
Internship/Projects
We train students and researchers to do articles/reviews/chapters and even PhD.

Who We Are
Incepted in 2018 by a team of young and proficient professionals, Xcellogen Biotech India Pvt Ltd is a young and focused Life Science company based out in Thiruvananthapuram, Kerala, with a vision to be the Technology & Knowledge partners for Indian research & Biotechnology community.
Xcellogen Biotech endeavors to bring to researchers and Students innovation-focused organizations cutting edge tools for applications across Microbiology, Herbal Medicine, Pharmacology, Molecular Genetics and much more.
Read moreOur Vision
- To understand the key demands in biotech sector of academia, industry and society and bridge the gap existing by providing healthy education channels
- Develop a strong platform for gaining practical exposure of the systems in biotechnology
- Nurture and engage young learners with the right skill set to work on scientific innovation and development
- To create networks to bring the intellectual outputs of researchers to international limelight
Our Mission
- Work towards novel, affordable and cost-effective product development and address the existing needs in the biotech sector through sustainable processes and technologies


Lab Trainings
Project / Dissertation Training
Molecular Biology, Microbiology, Nano-biotechnology, Bioinfformalus, Food Technology, Phytochemistry, Biochemistry, Herbal Drug Formulation (According to client request), Enzymology
Read MoreJob Training Program
Molecular Biology, Microbiology, Nano-biotechnology, Bioinfformalus, Food Technology, Phytochemistry, Biochemistry, Herbal Drug Formulation (According to client request), Enzymology
Read MoreWorkshop & Scenaries
Molecular Biology, Microbiology, Nano-biotechnology, Bioinfformalus, Food Technology, Phytochemistry, Biochemistry, Herbal Drug Formulation (According to client request), Enzymology
Read More
Our Services
We provide all aspects of medical practice for your whole world, including general check-ups or assisting you with specific injuries.
Inspiring Stories!
"On behalf of our management it gives me great pleasure in conveying our appreciation to Xcellogen Biotech team in the way you have handled the lecture."
“We feel this project provided a better platform for learning Nanotechnology and Plant Biotechnology”
“Xcellogen Biotech is a Educational Research Company where innovative idea and technical researches are main aim.”
“Working with xcellogenbiotech will be best when u r a researcher... U will get to learn everything here. How to manage things,How to handle lab, and will get a good support lead.”
“Working atmosphere is good with nice infrastructure and ambiance. You will have a good scope of learning and I am lucky enough to find a good project.”
“Based on your project you will get a chance to learn more again it is based on your interest and push.”

Badri Prasad Sarangi
BTech Biotechnology, 2nd Year, VIT Vellore.

Sayan Kundu
BTech Biotechnology, 3rd Year, VIT Vellore.

Dr. A. Dhanesh Gandhi
Department of Biotechnology, Thiruvalluvar University, Serkkadu, Vellore.

Adyasha Nayak
BTech Biotechnology, 2nd Year, VIT Vellore.

Priya Sivanandam
Biotechnologist

Sarbajit Ray
BTech Biotechnology, 2nd Year, VIT Vellore.

Certificate Training
Today the hospital is recognised as a world renowned institution, not only providing outstanding care and treatment, our goal is to deliver quality care in a respectful & compassionate manner. We strive to be the first and best choice for healthcare.
- Lab Skill Development Program
- Student Disscration Program
- Student Internship Program